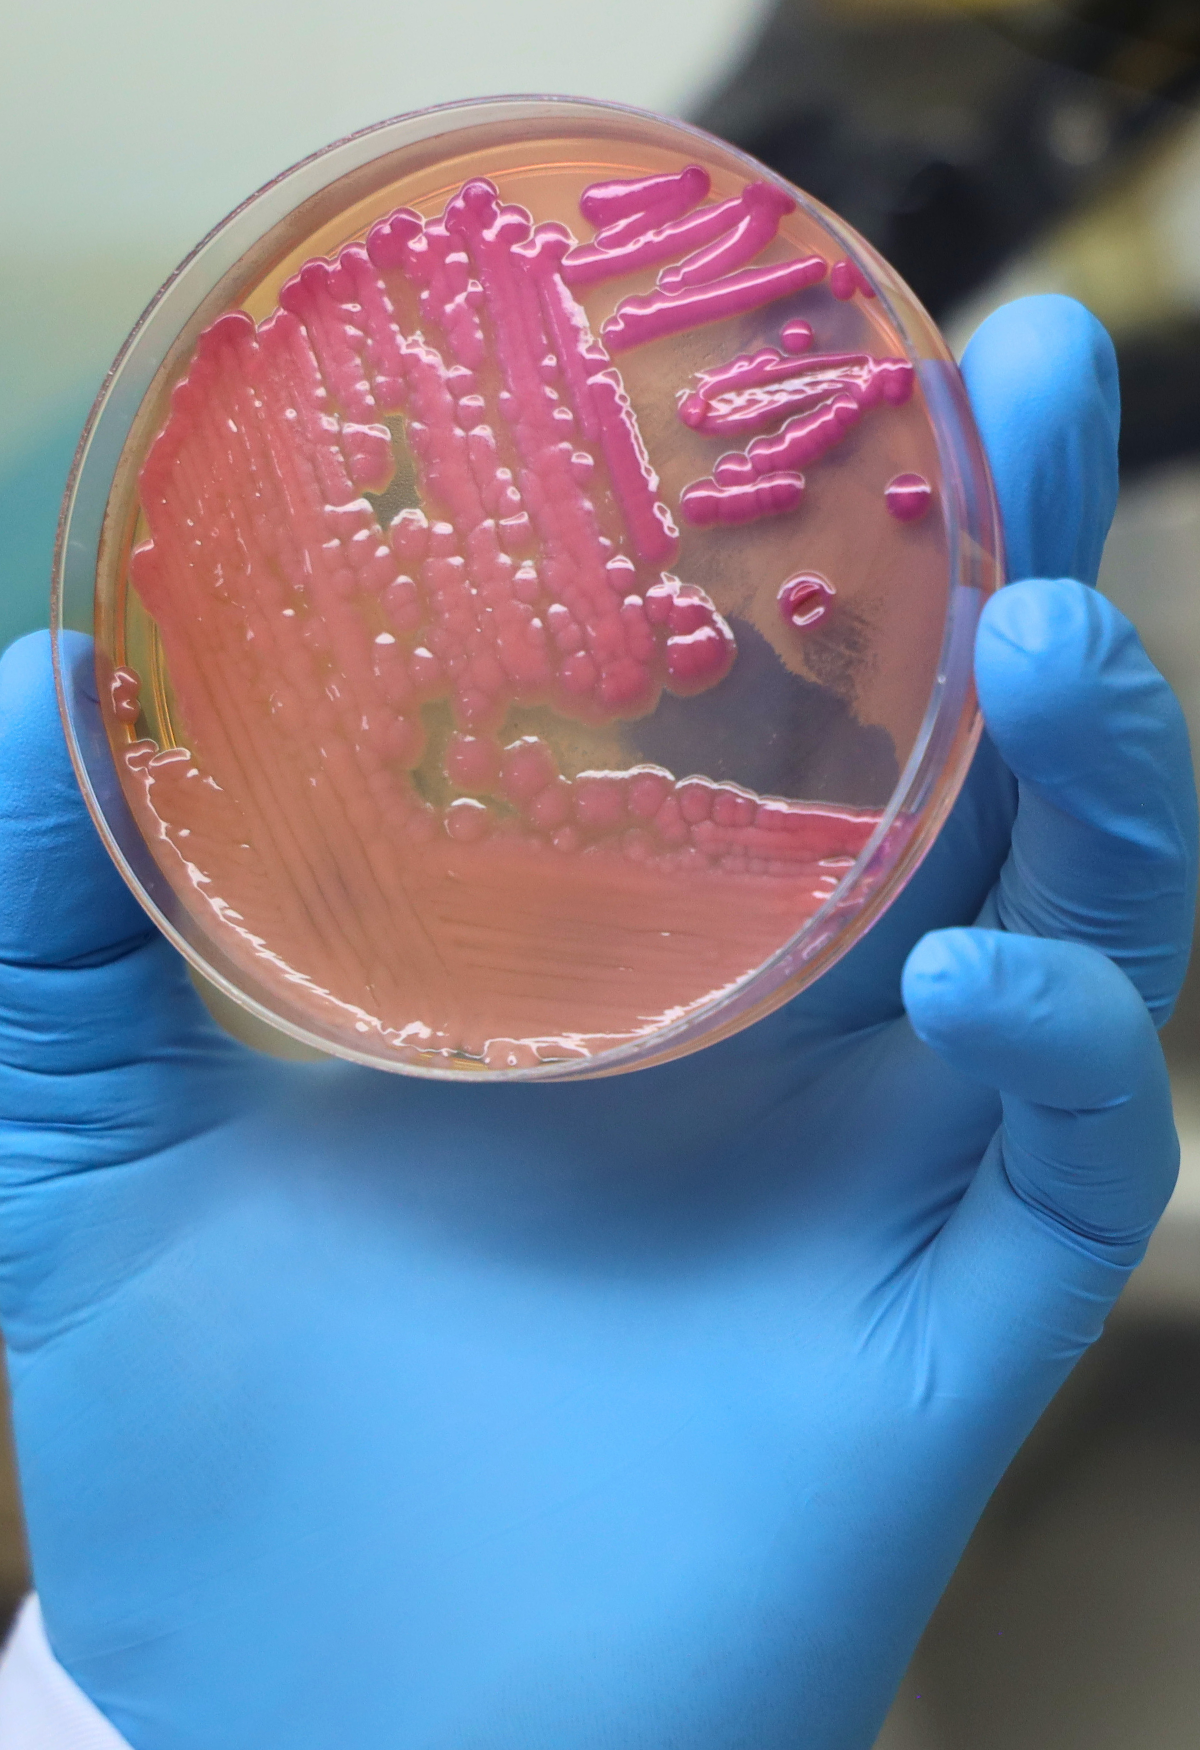

Biblioteca - consulta ao acervo
Coordenador
PÓS-GRADUAÇÃO STRICTO SENSU
Av. Costábile Romano, 2201 - Ribeirânia
Unaerp - Bloco C
Telefone: (16) 3603-6774 / 3603-7010
E-mail: dpg@unaerp.br
Ribeirão Preto - SP
CEP - 14096-900
Unaerp - Bloco C
Telefone: (16) 3603-6774 / 3603-7010
E-mail: dpg@unaerp.br
Ribeirão Preto - SP
CEP - 14096-900
MESTRADO EM SAÚDE E EDUCAÇÃO
|
Modalidade |
Presencial |
|
Nível de formação |
Mestrado |
|
Duração |
24 meses |
|
Avaliação |
CAPES: Nota 3 |
|
Campus |
Ribeirão Preto |
NOTÍCIAS

25 de setembro de 2025

28 de abril de 2025

21 de fevereiro de 2025
10 de dezembro de 2024
.png)
29 de julho de 2024

21 de junho de 2024

21 de junho de 2024

19 de março de 2024

01 de fevereiro de 2024




















